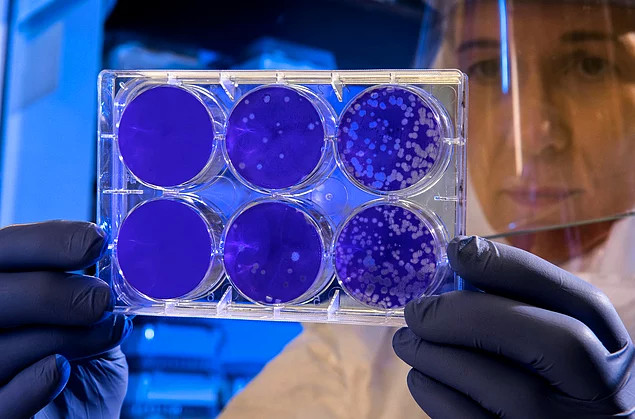
Virüset dhe Bakteret mund të qëndrojnë të ngrira për miljona vjet  e kurrë nuk e humbasit efektshmërinë e tyre mbasi shkrijnë. Pra një virus i para 3mije vjetëve mund të jetë fatal për njerëzimin.

1,323
lexime
lexime
Dija në kohët e sotme është një nga domosdoshmëritë e jetës. Ne çdo ditë mesojmë gjëra të reja në lidhje me veten, njerëzit apo ambjentin që na rrethon, gjithsesi disa lloj informacionesh na zgjerojnë horizontin kaq shumë saqë na bëjnë të kuptojmë më mirë ambjentin që na rrethon. Këto 16 dije në dukje të thjeshta mund që një ditë të na shpëtojnë jetën, apo të frymëzojnë kërkimet tuaja shkencore!
Virüset dhe Bakteret mund të qëndrojnë të ngrira për miljona vjet e kurrë nuk e humbasit efektshmërinë e tyre mbasi shkrijnë. Pra një virus i para 3mije vjetëve mund të jetë fatal për njerëzimin.
"Që prej vitit 2007, të paktën 20 gjurmë këmbësh të ndryshme dhe teke janë gjetur në brigjet e Detit Salish."

Nëse ju pickon kërmilli me guackë si kon nuk do të ndjeni aspak dhimbje.Ama nëse antidoti nuk gjendet, mund të përballeni me pasoja vdekjeprurëse ...

Punëtorët e anijeve Essex vazhduan rrugën e tyre larg nga ishujt sepse kishin frikë nga piratët dhe kanibalët pas aksidentit të tyre, por për ironi ... Ata hëngrën njëri-tjetrin për të mbijetuar mbasi ju mbaruan ushqimet!!!

Deri në vitin 1987, Akademia Amerikane e Pediatrisë e konsideronte etike të operonte foshnjat e porsalindura pa anestezi.

Ekziston një specie e baktereve në botë që hyn në gojën e peshkut dhe mbasi i hanë gjuhën peshkut formojnë gjuhë të reja .

Ndjesia juaj e fundit që shuhet para se të vdisni është të dëgjuarit. Pra, gjëja e fundit që do të përjetoni para se të vdisni mund të jetë klithja apo bërtitja e frikshme e atyre që janë përreth jush.

Një torrnado mesatare e flakës mund të arrijë në të njëjtën forcë si një uragan me shpejtësi 265 kilometra në orë.
Nëse rrini për 2-4 orë nën një temepaturë 594 gradësh ju mund të ktheheni në hi aq të imët sa asnjë nuk do të jetë në gjendje të gjejë as ADN-në tuaj.

Mamba e zezë është gjarpri më i shpejtë në botë dhe mund të përparojë me një shpejtësi prej 20 km në orë.
Vrasësi serial Richard Ramírez e perceptoi si një ftesë për të hyrë kur gjente dritaret gjysëm të hapura dhe dyert e shkyçura në rrugë.

Trupat e grave në Egjiptin e lashtë mumifikoheshin më vonë se burrat. Trupat e tyre u mbaheshin në shtëpi derisa fillonin të kalbeshin ... Arsyeja për këtë ishte të sigurohej që mumifikuesi mos të jetë në gjendje të përdhunojë kufomën.

Ekziston një specie merimangash në botë që po ju pickoi ju bën të keni një ereksion të dhimbshëm për 3 orë dhe më pas shkakton vdekjen tuaj...
Karavidhet nuk plaken kurrë dhe qelizat e tyre nuk vdesin. Nëse arrijnë një madhësi shumë të madhe, ata vdesin nga lodhja sepse aplikojnë shumë energji në guackën e tyre.

Perceptimi juaj për gjërat përreth jush, si mendërisht ashtu edhe vizualisht, mund të ndryshojë me atë që shihni nëse jeni nën efektin e iluzionit të quajtur Troxler.
Kështu që nuk është e çuditshme të shihni ndonjë monstër kur shiheni në pasqyrë për një kohë të gjatë.




















Comments
0 comment